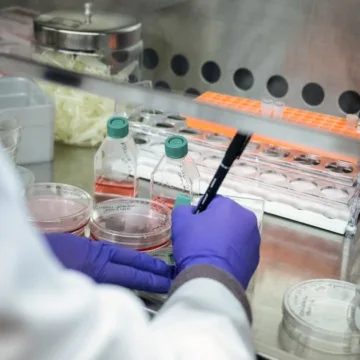
Judge blocks Trump administration from cutting research funding after 22 states sue

MIAMI — If any husbands or boyfriends mess up Valentine’s Day this week, it’s not because of a shortage of flowers. In the run up to Feb. 14, agricultural specialists at Miami International Airport have processed about 940 million stems of cut flowers, according to U.S. Customs and Border Protection. Around 90% of the fresh...
Category: Breaking News
Two children die in Detroit cold while sleeping in van, police say
Two children in Detroit died of suspected exposure to the cold after being found unresponsive in the van where the family was living Monday, police said. The children, ages 2 and 9, were discovered not breathing by their mother at around noon, Detroit police Capt. Nathan Duda said. They were separately taken to a hospital,...
1 dead in Arizona after jet hits plane parked near Scottsdale airport
One person has died and three others were injured after an arriving midsize jet hit a plane on the ground near Scottsdale Airport in Arizona on Monday, authorities said. The crash “off the runway” was reported at 2:39 p.m., and first responders found one person dead on arrival, said Scottsdale Fire Capt. Dave Folio. The...
Justice Department orders charges against NYC Mayor Eric Adams dismissed
Acting U.S. Deputy Attorney General Emil Bove has ordered federal prosecutors in New York to drop corruption charges against New York City Mayor Eric Adams, a senior Justice Department official said Monday evening. The order is for all charges against Adams to be dismissed, and the dismissal is without prejudice, the official said, meaning charges...
CDC confirms Nevada dairy worker infected with different bird flu strain
A strain of bird flu spreading among dairy cows in Nevada has infected a dairy worker in the state, the Centers for Disease Control and Prevention said Monday. The patient, who’d been working with sick cows, was found to have a strain of bird flu called D1.1, which has long been circulating in wild birds....
Judge blocks Trump administration from cutting research funding after 22 states sue
A federal judge temporarily halted the Trump administration’s radical changes to how the National Institutes of Health pays for biomedical research, putting on hold a plan to slash research funding paid out by the federal government. Twenty-two state attorneys general filed a lawsuit Monday against the plan, which would limit how it pays out universities...
Elon Musk and investors offering $97.4 billion for control of OpenAI, WSJ reports
Elon Musk is leading a group of investors in offering to buy control of OpenAI for $97.4 billion, the Wall Street Journal reported on Monday. The bid is for the nonprofit that oversees the artificial intelligence startup, the Journal reported, adding that Musk’s attorney, Marc Toberoff, said he submitted the offer on Monday. The WSJ cited a statement...
Trump expected to pardon former Illinois Governor Rod Blagojevich
President Donald Trump is expected to pardon former Illinois Gov. Rod Blagojevich, according to a White House official. Blagojevich, who was a Democrat while in office, had served eight years in prison on charges stemming from his effort to sell Barack Obama’s Senate seat after Obama won the 2008 presidential election. Trump commuted Blagojevich’s 14-year sentence...
Pentagon to ban trans people from joining military, pauses gender-transition procedures
The U.S. military will no longer allow transgender individuals to join the military and will stop performing or facilitating procedures associated with gender transition for service members, according to a memo from Defense Secretary Pete Hegseth filed in court on Monday. President Donald Trump signed an executive order last month that took aim at transgender...
Judge extends freeze on Trump’s unprecedented plan to get millions of federal workers to resign
A federal judge in Boston on Monday continued his pause of the Trump administration’s unprecedented plan to get millions of federal workers to resign “until I respond to the issues presented,” he said. U.S. District Judge George A. O’Toole Jr. had temporarily halted the administration’s plan to offer mass buyouts to millions of federal workers on...